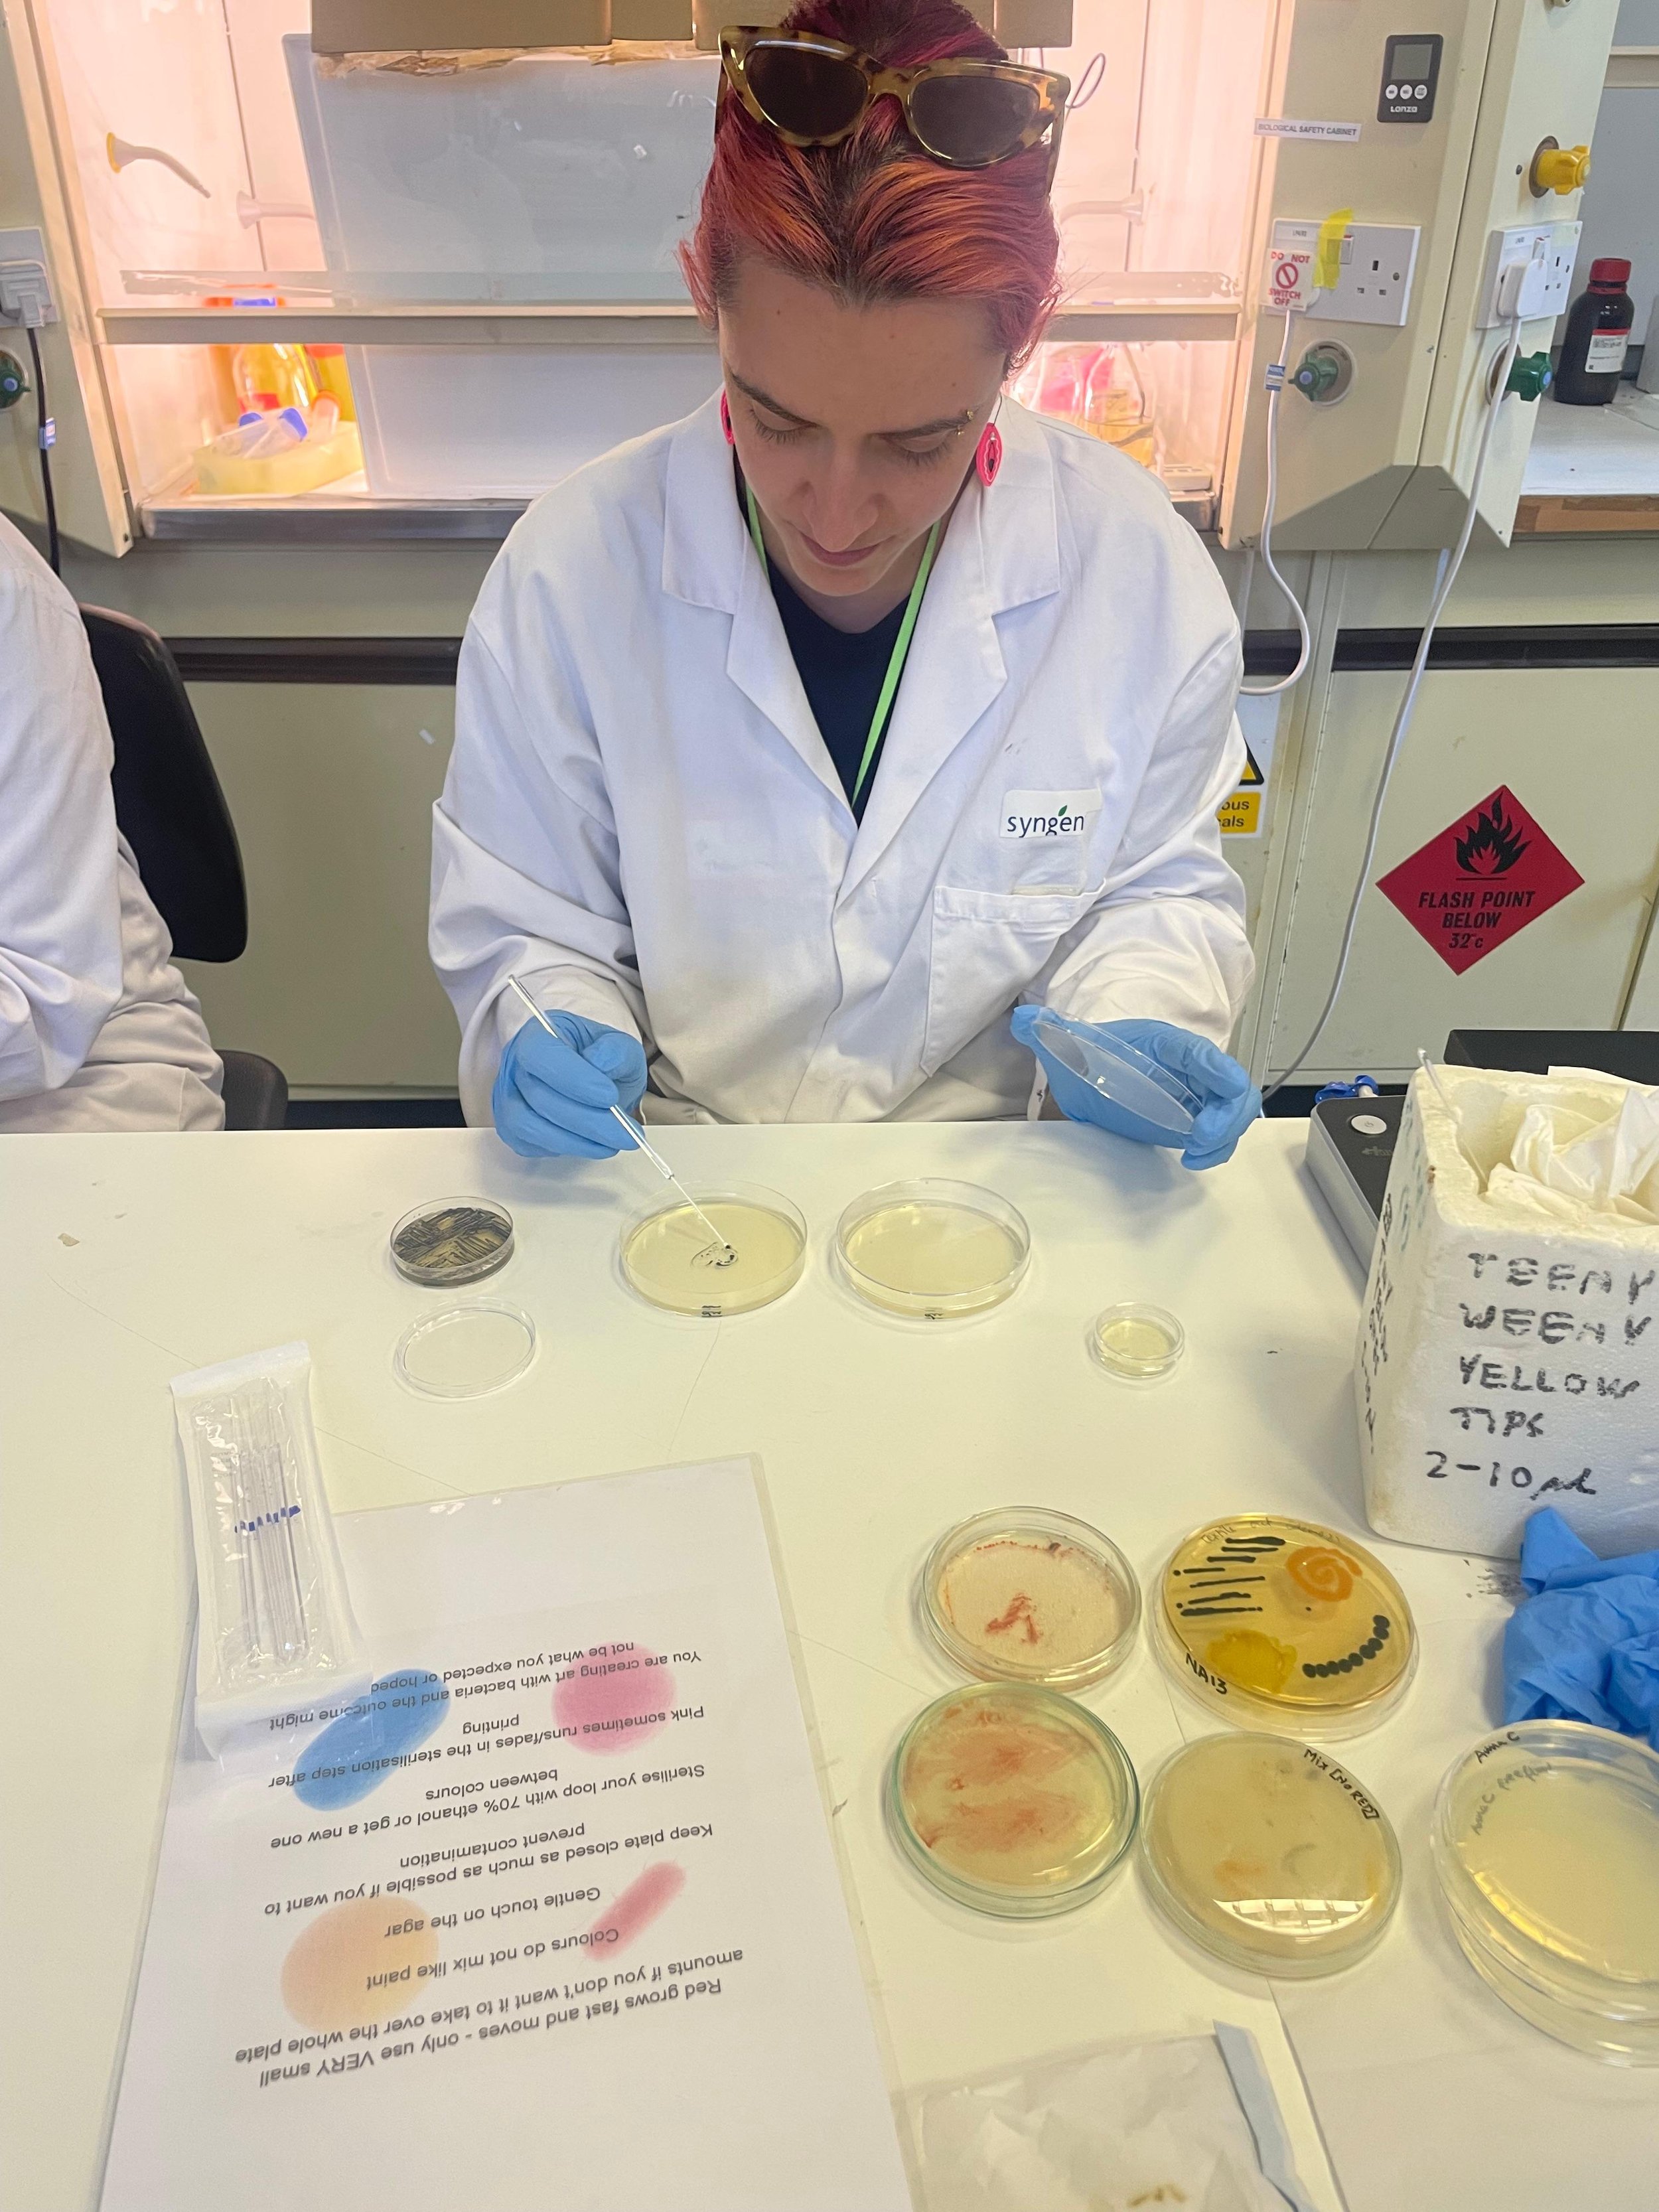
WhatsApp Image 2025-07-30 at 11.18.33.jpeg

Growing Culture: LGBTQIA+ Art Therapy Workshops
Growing Culture is a unique series of workshops combining art psychotherapy group work with hands-on science lab enquiry. Using a range of art materials and bacteria as our mediums, these workshops are for LGBTQIA+ (lesbian, gay, bisexual, transgender, queer, intersex, asexual and other related identities) people to explore concepts of personal growth, increase community connection and engage their curiosity in celebration of themselves.
The workshops will take place over 2 consecutive Saturday afternoons and attendance at both dates is required. During the workshops you will have the opportunity to meet other LGBTQIA+ people, use lab equipment like microscopes, learn more about the different properties of bacteria, grow your own bacteria and use a range of art materials to make art in response to themes of identity, growth and survival. No prior experience or skill in art making or science is required, only a curiosity to see everyday things in a new way.
When: Saturday 20th & 27th September 2025 | 1:30pm - 6pm
(Attendance of both dates is required)
Where: Summerhall, Edinburgh, EH9 1PL - The workshops will take place between the ASCUS Lab and the Art Psychotherapy studio sites at Summerhall.
Cost: Free. We have a small allowance to cover local travel costs if this is a barrier for you to attend.
The workshops are suitable for LGBTQIA+ people aged 18 and over, including those who may be questioning their sexuality and/or gender. The workshops are designed for people who are interested in engaging with their creativity to connect with others in a small group (approx. 8 people) setting. Whilst there is no expectation for people to share anything they do not feel comfortable with, though some discussion in pairs and the whole will be encouraged. Please read our safer space expectations for more information on conduct.
These workshops are not suitable for those currently in crisis and/or unable to commit to attend both dates of the workshops.
The workshops are planned and delivered by ASCUS Art & Science General and Lab Manager, Dr. Keira Tucker (she/her) and queer Art Psychotherapist Alison Wren(she/they).
How to book
By booking a ticket you are reserving a place at the workshops. Alison will then be in touch via email to confirm some details, including an opportunity to clarify any access needs and answer any questions which might help you know more about what to expect. At this point your place will then be confirmed.
Places are offered on a first come first served basis, however we are also operating a waiting list. We will also be delivering a further set of the workshops in September 2025 if you miss out on this initial opportunity.
We are able to offer these workshops for free thanks to funding from the Awards for All Community Fund.
#NationalLottery